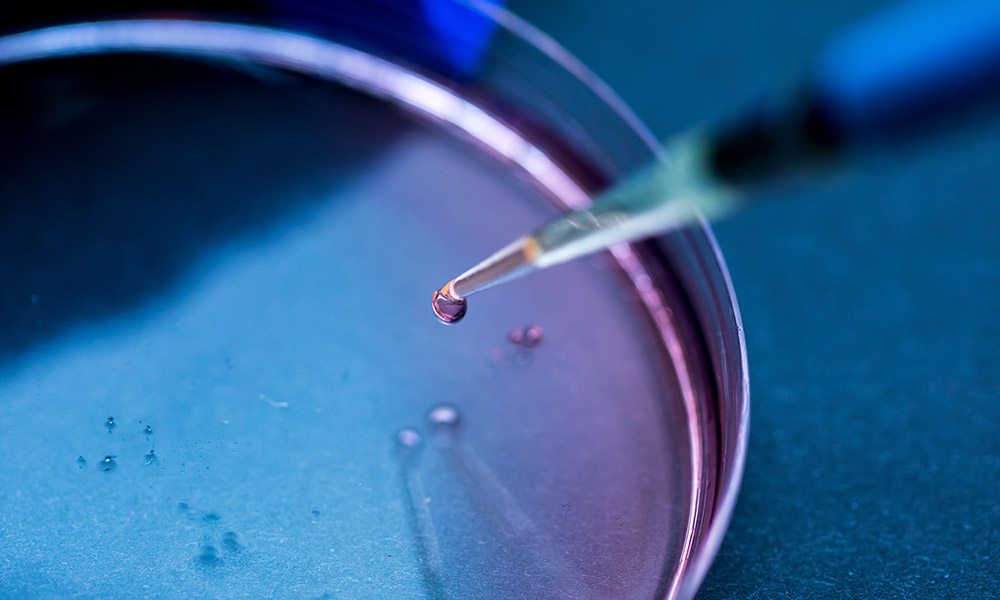
timeline-4

P2i
What we do
The 4 pillars of P2i
At P2i, we believe everyone deserves to live in safer, healthier environments. That’s why we take a caring, multi-faceted approach—certifying trusted products, offering expert training, and creating forward-thinking services designed for both healthcare professionals and the people they serve.
Our work is guided by four core pillars: Research Interpretation, Education, Advocacy, and Health System Integration. We take complex scientific findings and translate them into clear, meaningful guidance that’s easy to understand and act upon. For healthcare professionals, this means being equipped with the latest science to confidently support their patients. For consumers, it means having reliable information they can trust to make healthier choices every day.
At the heart of everything we do is a simple goal: to make knowledge accessible, empower people, and bring health and safety within reach for all.

Safety Seal
We make complex science understandable. Our role is to interpret and translate the latest research—helping both consumers and healthcare professionals cut through overwhelming information and apply science-backed insights to real-world health decisions. We can then certify products that have passed our rigorous testing.

Education
Grounded in science, we turn research into practical guidance. We equip clinicians with the tools to test and treat patients effectively, while empowering patients with the knowledge they need to make informed, confident choices about their health.

Advocacy
By partnering with like-minded organizations, we advocate for healthier families, more innovative health systems, and stronger government regulations. Our goal is to shift responsibility away from the individual and toward the industries and companies that shape our daily environment.
Laboratory Testing
We believe knowledge is power. We operate a specialized testing lab that identifies individual environmental exposures. Every test comes with personalized, clinician-guided feedback to help you understand your results and take informed action.
Curriculum
Our online curriculum provides clear and concise instruction for both healthcare providers and the general public.
Testing
We offer a testing lab to identify environmental exposures, empowering you with the knowledge you need. All tests include clinician-guided feedback.
Clinician Certification
Our clinicians undergo a comprehensive certification process, enabling them to effectively guide patients, interpret results, and provide expert education and guidance.
Product Certification
Products that pass our testing based on FIGO guidance can carry the P2i seal of approval, verifying they are free from chemicals of immediate concern.
Product Line
The P2i website will soon feature products that meet rigorous standards for a clean and healthy environment.
